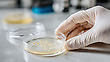
17111344

17111343



| 파일타입 | 편집이미지 |
|---|---|
| 제공파일 | JPG 원본 : (6000px * 3363px / 1 MB) 제작소프트웨어 : Photoshop CS3 | JPG 웹 : (1000px * 561px / 128 KB) 제작소프트웨어 : Photoshop CS3 | JPG : (3000px * 1682px / 909 KB) 제작소프트웨어 : Photoshop CS3 |
 제작소프트웨어 버전 이하에서 파일이 열리지 않을 수 있습니다.
제작소프트웨어 버전 이하에서 파일이 열리지 않을 수 있습니다.
콘텐츠 테마
ㆍ공개일 : 2025년 12월 08일